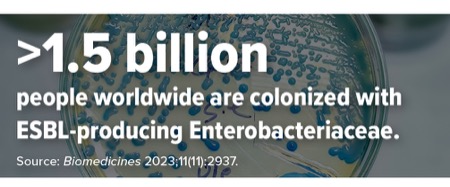
image

The global rise of multidrug-resistant (MDR) Enterobacterales—particularly those producing extended-spectrum beta-lactamases (ESBLs) and metallo-beta-lactamases (MBLs) such as New Delhi metallo-beta-lactamase (NDM)—represents a clinical challenge with limited therapeutic options, especially because community transmission is also increasing, said Ashlan Kunz Coyne, PharmD, MPH, an assistant professor of translational and clinical science in the Department of Pharmacy Practice and Science at the University of Kentucky College of Pharmacy, in Lexington.
“We are treating these infections now on a regular basis, and gone are the days where you just have patients who developed them after hospitalization. About half of ESBL infections are now being transmitted out in the community, and they are likely going to have co-resistance with our go-to agents, leaving us with just the IV carbapenems,” she said at the MAD-ID 2025 Annual Meeting, in Orlando, Fla.
Approved by the FDA in February 2024 to treat complicated UTIs (cUTIs), cefepime-enmetazobactam (Exblifep, Allecra Therapuetics) is the first cefepime and beta-lactamase inhibitor combination for MDR Enterobacterales (Future Microbiol 2025;20[4]:277-286). In the pivotal ALLIUM clinical trial, the combination demonstrated superiority over piperacillin-tazobactam in clinical cure and microbiological eradication (79.1% vs. 58.9%) (JAMA 2022;328[13]:1304-1314).
“It’s potent against our ESBL isolates. Of more than 2,000 isolates that were tested, over 95% are susceptible, including the approximately 200 ESBL isolates. It was also tested against AmpC-producing Enterobacterales, with again about a 90% to 95% susceptible range,” Dr. Kunz Coyne said. “But there is a subset of KPC [Klebsiella pneumoniae carbapenemase] producers in which it shows reduced effectiveness, dropping closer to 60%, and is inactive against MBL-producing bacteria [Antimicrob Agents Chemother 2019;63(7):e00514-19].”
The combination also has potential against nosocomial pneumonia, prosthetic joint infections and bloodstream infections, but more ESBL data in those indications are needed, she said.
Sulopenem (Orlynvah, Iterum Therapeutics)—approved in October 2024 to treat uncomplicated UTIs caused by Escherichia coli, K. pneumoniae or Proteus mirabilis—is the first U.S. oral penem. It became available in August. It is dosed with probenecid, which enhances oral bioavailability by reducing renal excretion, and should be taken with food to maximize bioavailability.
“It’s specifically approved for patients who have limited to no other oral antibacterial treatment options,” Dr. Kunz Coyne explained. In clinical trials, sulopenem demonstrated noninferiority to ciprofloxacin and amoxicillin-clavulanate for uncomplicated UTIs, but it did not meet noninferiority criteria in cUTI cases due to the occurrence of asymptomatic bacteriuria (Clin Infect Dis 2023;76[1]:66-77; Open Forum Infect Dis 2025;12[suppl 1]:ofae631.1295; Clin Infect Dis 2023;76[1]:78-88).
“I think there will definitely be opportunities where you have a stable patient who is ready to be transitioned from IV therapy to oral and go home and finish up their treatment, and this could definitely be an agent for us to turn to,” she said.
Unlike sulopenem, tebipenem (Orapenem, Spero Therapeutics/GSK), a pipeline oral carbapenem, does not require probenecid and does not need to be taken with food. In May 2025, GSK announced it was stopping the phase 3 PIVOT-PO trial (ClinicalTrials.gov Identifier: NCT06059846) of tebipenem in patients with cUTIs early because it had met efficacy goals. If approved by the FDA, it will be the first oral carbapenem available for cUTIs.
There are some limitations to the data on newer agents, Dr. Kunz Coyne noted. “The trials excluded immunocompromised patients and those with serious infections, so this would be an excellent area for real-world data. We also need more robust evaluation of ESBL producers, since those only accounted for about 20% of trial isolates and those infections are much more prevalent in real-world scenarios.”
Additionally, none have MBL activity; currently, there are no FDA-approved beta-lactamase inhibitors specifically targeting MBLs, which are spreading rapidly around the globe. In the United States, particularly in the Southwest, epidemiological data have shown a significant increase in NDM-producing K. pneumoniae isolates (Infect Dis Now 2025;55[3]:105052). In a 2023 study involving data from 74 U.S. medical centers, NDM-Enterobacterales comprised an increasing proportion of carbapenem-resistant Enterobacterales, going from 3.8% in 2019 to 20.4% in 2021, with most of those (88%) being NDM producers.
The emergence of NDM variants poses a significant threat to treatment options, as these enzymes hydrolyze nearly all beta-lactam antibiotics, said Pranita Tamma, MD, an associate professor of pediatrics at Johns Hopkins University School of Medicine, in Baltimore, and a lead author of the Infectious Diseases Society of America’s (IDSA’s) 2024 Guidance on the Treatment of Antimicrobial Resistant Gram-Negative Infections. “NDM-producing Enterobacterales were first detected in 2008 in K. pneumoniae and E. coli isolates from a patient returning to Sweden from India. By 2010, they were widespread in India, and now they’ve disseminated to become a global problem,” she said. “New variants are evolving quickly, with over 600 to date. These NDM producers are increasingly able to thrive in states of zinc scarcity, which is typically the case in human infections, which is one of the reasons we sometimes see much more aggressive infections than we would otherwise expect.”
One antimicrobial that has demonstrated efficacy against NDM producers is aztreonam-avibactam (ATM/AVI; Emblaveo, AbbVie), she said. “Its molecular structure enables it to fit nicely in the groove of the NDM enzyme, the active site, without making the proper points of contact with zinc molecules, and it is able to escape hydrolysis.”
In February 2025, the FDA approved ATM/AVI with metronidazole to treat complicated intraabdominal infections, including those caused by MBL–producing Enterobacterales. The IDSA guidance lists ceftazidime-avibactam (CAZ/AVI; Avycaz, AbbVie) with aztreonam as one of two preferred regimens (along with monotherapy cefiderocol [Fetroja, Shionogi]), noting CAZ/AVI itself is inactive against MBLs; but when paired with aztreonam, this combination overcomes those enzymes’ resistance effectively (Clin Infect Dis 2024:ciae403).
“ATM/AVI is a promising treatment for MBL-producing Enterobacterales, although since most of the preclinical data and clinical data that led to its approval focus on E. coli, we probably need more data to show the same is true for MBL-producing K. pneumoniae infections, which are really skyrocketing in the U.S.,” Dr. Tamma said. “The next version of the IDSA guidelines will likely state that aztreonam-avibactam or cefiderocol are both considered preferred options, but if you don’t have aztreonam-avibactam, ceftazidime plus aztreonam could be used as a substitute. I think ATM/AVI is a promising antibiotic with activity against MBL-producing Enterobacterales.”
Two other promising combinations, cefepime-taniborbactam (FEP/TAN; VenatoRx/Melinta) and cefepime-zidebactam (FEP/ZID; Wockhardt), have not yet been submitted for FDA review.
In the CERTAIN-1 trial (NCT03840148) submitted to the agency, CEF/TAN achieved a composite microbiological and clinical response rate of 70.6% versus 58.0% with meropenem in patients with cUTIs (N Engl J Med 2024;390[7]:611-622). “Unfortunately, we don’t have published compassionate-use cases to evaluate and the clinical trial did not report on any NDM-producing cases, so we are lacking clinical data for CEF/TAN against NDM-producing infections. However, this drug is expected to cover both NDM-producing Enterobacterales and VIM [Verona integron-encoded metallo-beta-lactamase]-producing Pseudomonas aeruginosa, another type of MBL, which makes it a very necessary agent.”
When it was first submitted to the FDA, the agency requested additional data about the drug chemistry, testing methods and manufacturing process, she noted. “But the concerns did not appear to be related to safety of efficacy. My hope is the company will resubmit to the FDA within the next year.”
FEP/ZID is an exciting drug with a unique mechanism of action in that it has an affinity for multiple penicillin-binding proteins (PBPs) and appears successful at evading MBL hydrolysis—even in the presence of mutant PBP3—a growing problem in NDM-producing E. coli that leads to resistance to other MBL active drugs including cefiderocol, ATM/AVI and CEF/TAN. Results of a phase 3 trial of FEP/ZID in UTIs have not yet been published, but Dr. Tamma shared early data provided to her by Wockhardt, which indicated that on the primary end point of composite cure (clinical and microbiological), FEP/ZID was superior to meropenem at 89% versus 68%. “Although it is unpublished data and we don’t know the nuances, there also appear to be over 50 compassionate-use cases specifically for NDM-producing Enterobacterales, with generally favorable outcomes,” she said. “We obviously want to see more data to confirm this is the case, but these outcomes do look quite exciting.”
Drs. Kunz Coyne and Tamma reported no relevant financial disclosures.
This article is from the August 2025 print issue.